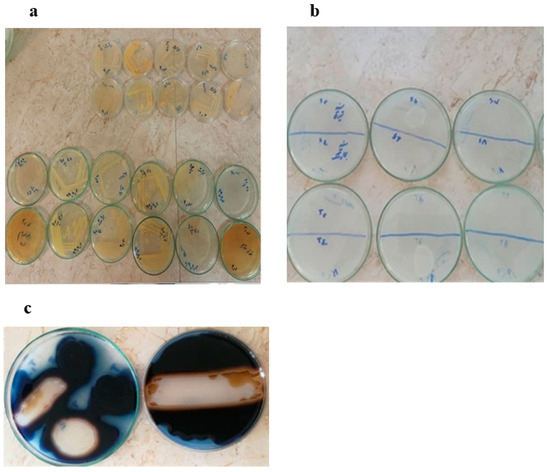

Abstract
α-amylases are one of the most common and important industrial enzymes widely used in various industries. The present study was conducted with the aim of isolating and identifying symbiotic α-amylase enzyme-producing bacteria in the intestine of Silago Sihama and Rasterliger Canagorta fish living in Qeshm Island, Hormozgan. The intestinal symbiotic bacteria of these species were isolated using nutrient agar culture medium; then, α-amylase producing bacteria were screened using a special culture medium containing starch and the Lugol’s solution test. The α-amylase enzyme activity of enzyme-producing bacteria was measured using the starch substrate. Finally, bacteria with the highest enzyme activity were selected and identified by the 16S rRNA gene sequence analysis. The results showed that out of 22 isolated bacteria, 10 were able to grow in a special culture medium, and 5 strains of these 10 bacteria had the ability to produce relatively stronger halos. The four bacterial strains belonging to the genus Bacillus that had the highest α-amylase enzyme activity were identified and registered in the NCBI gene database as B. subtilis strains HR13, HR14, HR15, and HR16. Among these four strains, two strains of B. subtilis, HR13 and HR16, displayed high enzyme activity and maximum activity at 60 °C at pH values of 5 and 7, respectively. α-Amylase enzymes isolated from marine symbiotic bacteria of Bacillus species can be considered potential candidates for application in various industries.
1. Introduction
Oceans cover 71% of the earth’s surface and are home to a diverse range of species, such as algae, bacteria, fungi, sponges, and fish. The sea is a challenging place to inhabit because it has both deep and shallow areas with different temperatures and pressures, salinity changes, different pHs, light, hydrostatic pressure, and the distribution of different nutrients, all of which lead to a wide variety of marine organisms with unique characteristics [1,2,3].
Marine microorganisms are a promising source for discovering novel enzymes because of their distinctive natural environments, physiological traits, distinctive metabolic processes, and use of varied nutrients [4,5]. Marine bacteria are a diverse group of marine microorganisms that have developed physiological adaptations in response to various environmental factors and evolutionary processes. They also produce a variety of hydrolyzing enzymes, such as amylases, lipases, and proteases, which may have applications in contemporary biotechnology [6]. The main benefits of employing microorganisms for enzyme synthesis over plants and animals are rapid growth, huge production capacity, and simple enzyme extraction from bacteria [5,6].
The buoyancy of fish in water causes bacteria to cover the outer surface of their bodies, and as a result, fish are in continuous contact with the microorganisms that cover their bodies. Some of these microorganisms do not live on the surface of the fish but are instead found as part of the microbes that live within the fish body, such as the oral cavity [7]. The combination of all environmental factors for fish symbiotic bacteria results in the development of enzymes with exceptional features of the bacteria in this milieu [8,9].
Amylases are one of the most important sources of industrial enzymes with many applications in various industries, such as pharmaceuticals, food industries, auxiliary food preparation, detergents, papermaking, and textiles. They provide the hydrolysis of starch into small sugar units of dextrin or smaller glucose polymers and are classified into three groups, namely α-amylases, β-amylases, and γ-amylases. α-amylases cleave the bond (α (1→4)) between adjacent glucose units in the linear chain of amylose in starch carbohydrates [10]. Since α-amylase has multiple cleavage sites, α-amylase is faster than β-amylase. In addition, α-amylase enzymes have the necessary stability against high temperatures, especially α-amylase synthesized from Bacillus subtilis and Archaea bacteria species, which are resistant to heat [11]. Various physical and chemical factors, such as temperature, pH, incubation period, carbon sources as inducers, surfactants, nitrogen sources, phosphate, and different metal ions, affect the production of α-amylase [12].
Although the production of α-amylase enzyme by Gram-negative bacterial strains such as B. sp., Aeromonas sp., and Stenotrophomonas sp. has been reported, the production of α-amylase isolated from fish intestinal bacteria is still ambiguous and has not been widely studied [13]. So far, no research has been performed on the isolation of α-amylase enzyme-producing bacteria coexisting with the digestive systems of Sillago sihamas and Rastrelliger Kanagurta fish from the southern coasts of Iran. In this study, the symbiotic bacteria of the intestine of Sillago sihamas and Rastrelliger Kanagurta fish were isolated, and then α-amylase enzyme-producing bacteria were screened, and those with the highest potential to produce α-amylase were identified by biochemical, morphological, and molecular methods, and finally, some biochemical characteristics of the enzyme were investigated.
2. Results and Discussion
2.1. Primary and Secondary Screening of α-Amylase-Producing Bacteria
In this study, 22 colonies were isolated from the collected samples of Rastrelliger kanagurta and Sillago sihama, of which 12 colonies were isolated from the intestine of Sillago sihama and 10 colonies were isolated from the intestine of Rastrelliger kanagurta. Among the twenty-two isolated bacterial strains, ten bacterial strains were able to grow in a special culture medium containing starch, five bacterial strains were able to produce strong halos by Lugol’s test, and other bacterial strains had a weak or moderate halo creation ability by Lugol’s test (Figure 1). The results revealed that these bacterial strains produce the α-amylase enzyme. In this experiment, starch was employed as a carbon source, and only those bacteria that had α-amylase enzyme were able to hydrolyze starch in this culture medium and grow in this specific medium (Table 1 and Table 2). For secondary screening, among the bacteria isolated from the intestines of Sillago sihama and Rastrelliger kanagurta, five bacterial strains with the highest degrees of halo formation (strong and medium) were chosen in the primary screening stage to measure enzyme activity. Meanwhile, four strains of B. subtilis strain HFBP08, B. subtilis strain ZIM3, B. subtilis strain SXK, and B. subtilis strain soil G2B had the highest amount of enzyme activity with the activity levels of 0.074, 0.048, 0.061, and 0.072, respectively. Finally, these four potential α-amylase enzyme-producing strains were selected for further analyses and molecular identification. The results indicated that Rastrelliger kanagurta and Sillago sihama fish species have rich sources of α-amylase-producing bacteria. The most potent bacterium among those producing enzymes was B. subtilis. In general, based on our findings, this bacterial strain can be a suitable source for the production of heat-tolerant amylase enzymes with high functional stability for use in industry. For example, α-amylase generated by these Bacillus species is used in the confectionery industry because of its temperature resistance, as well as starch liquefaction, processing, and application. They have a wide range of commercial applications and are especially useful in the food and pastry industries. Earlier research, similar to the current study, used a specialized growth medium containing starch for the first screening of bacteria that produce α-amylase. [14,15].
Figure 1.
Pure culture of isolated bacteria in nutrient agar medium (a), growth of α-amylase-producing bacteria in a specific solid culture medium containing starch (b), and a clear halo around the colony of α-amylase-producing bacteria using Lugol’s solution (c).

Table 1.
Evaluation of bacterial strains capable of producing α-amylase from the intestines of Sillago sihama.

Table 2.
Assessment of bacterial strains capable of generating α-amylase from the intestines of Rastrelliger kanagurta.
2.2. Molecular Identification of Potential α-Amylase-Producing Bacterial Strains
Identification techniques based on molecular studies are essential and accurate instruments for the proper characterization of microbial species. In this regard, four bacterial strains (HR13, HR16, HR15, and HR14) that had the highest α-amylase activity were identified by 16S rRNA gene analysis (Figure 2). All four strains with the capacity to produce α-amylase enzyme aligned most closely to the Bacillus genus, Bacillaceae family, and Bacillus subtilis species, according to the NCBI database’s analysis of the nucleotide sequence of the 16S rRNA gene of isolated bacteria. Based on these results, the bacterial strains (HR13, HR16, HR15, and HR14) have the highest similarity (99%) with B. subtilis strains HFBP08, ZIM3, SXK, and soilG2B. According to the results of 16S rRNA gene sequences, B. subtilis strain HR13, B. subtilis strain HR14, B. subtilis strain HR15 B., and B. subtilis strain HR16 were registered in the NCBI database with accession numbers MZ571841, MZ571838, MZ571839, and MZ571840, respectively. The phylogenetic tree of B. subtilis strains HR13, HR14, HR15 B., and HR16 isolated from the fish intestine in this study, as well as sequences available in NCBI for B. Methanobacterium formicicum, B. infantis strain C4, B. amyloliquefaciens strain TS.18 S.BK, B. velezensis strain CB02999, B. tequilensis strain HYM43, and B. mojavensis strain WSE-KSU305, were drawn and their evolutionary relationships were investigated (Figure 3). The evolutionary relationships of the strains obtained in this research with other Bacillus species, including B. infantis, B. amyloliquefaciens, B. velezensis, B. tequilensis, and B. mojavensis, are shown in a phylogenetic tree. Therefore, the present study shows that the strains belonging to B. subtilis are potential bacteria for the production of the α-amylase enzyme.

Figure 2.
Identification of 16S rRNA gene bands of enzyme-producing bacteria with a molecular weight of 1500 bp; Lad is a molecular marker.

Figure 3.
Phylogenetic tree of 16S rRNA nucleotide sequences in the analyzed strains (0.05 nucleotide replacement rate per site).
In 2014, Castro et al. isolated endophytic microorganisms symbiotic with leaves and branches of mangrove trees in Brazil from two mangrove species, namely Rhizophora mangle and Avicennianitida. Bacillus was the most isolated genus from mangrove trees in this region [16]. Similar to the present study, bacteria belonging to the Bacillus genus, including B. subtilis, B. stearothermophilus, and B. amyloliquefaciens, have been identified as potential α-amylase enzyme-producing bacteria [17,18,19]. B. amyloliquefaciens produces the most α-amylase enzyme in the world, and the α-amylase generated by this bacterium was the first enzyme employed in the industry for starch sweetening and liquefaction. [20,21,22]. Therefore, these findings demonstrate that bacilli have the unique capacity to synthesize α-amylase enzyme.
2.3. The Effect of Temperature and pH on the Activity and Stability of the α-Amylase Enzyme
The effect of temperature on α-amylase enzyme activity in B. subtilis strains HR13 and HR16 showed that both strains display maximum activity at 60 °C (Figure 4). At temperatures higher than 80 °C, the enzyme activity of both strains suddenly drops, so that at a temperature of 90 °C, the enzyme activity of the HR16 strain reaches almost zero.

Figure 4.
The effect of temperature on the enzyme activity levels of HR13 (■) and HR16 (▲) strains; the activity at the optimal temperature was taken as 100%.
The effect of different pH values on the enzyme activity of two strains, B. subtilis HR13 and B. subtilis HR16, shows their maximum enzyme activity at pH 5 and 7, respectively (Figure 5). The α-amylase enzyme activity of HR16 had a sharp drop after the optimum pH so that at pH values of 8 and 9, 35% and 28% of the initial activity of the enzyme was retained, respectively. In the case of the HR13 strain, the activity of the enzyme did not significantly decrease after reaching the optimal pH, and the enzyme maintained more than 75% of its initial activity in the range of pH 6–8.

Figure 5.
The impact of pH on the enzyme activity levels of HR13 (■) and HR16 (▲); the activity at the optimal pH was taken as 100%.
Irreversible thermal inactivation of enzymes isolated from B. subtilis strains HR13 and HR16 at temperatures of 80 and 90 °C demonstrated that at 80 °C with increasing incubation time (Figure 6), the amount of enzyme activity decreased, and after temperature incubation for up to 10 min, the enzyme activity in the HR13 B. subtilis strain reaches less than half. However, the enzyme of B. subtilis strain HR16 maintained > 50% of its initial activity after a temperature incubation for 20 min at 80 °C. Notably, after 60 min of temperature incubation, the activity of both enzyme strains reached almost zero.

Figure 6.
Thermal stability of the α-amylase enzyme activity of HR13 (■) and HR16 (▲) after incubating the enzymes in a water bath at 80 °C (a) and 90 °C (b) for different time periods.
At 90 °C, irreversible thermal inactivation of the enzyme decreases enzyme activity substantially faster than at 80 °C. After 30 min of temperature incubation, the enzyme activity of B. subtilis strain HR13 reaches less than 20% of its initial activity. About 22% of the enzyme’s initial activity was still present in the B. subtilis strain HR16 enzyme after 30 min of incubation at 90 °C. The irreversible inactivation of enzymes isolated from HR13 and HR16 was investigated and compared at an alkaline pH of 8 (Figure 7). Both forms of the enzyme exhibit a notable decline in activity at pH 8 with extended incubation times. The enzymes of strains HR13 and HR16 preserved 56% and 63% of their initial activity after 30 min of incubation at pH 8, respectively. At pH 12, the activity of the free enzyme decreased as the incubation time increased. After 60 min of incubation at pH 8, the free enzyme in both enzyme forms was reversible to about 18% of its initial activity.

Figure 7.
Irreversible inactivation of the α-amylase enzyme in HR13 (■) and HR16 (▲) after different time periods of incubation at pH 8.
3. Materials and Methods
3.1. Materials Used for the Collection of Short Fish Samples
All reagents were purchased from Merck Co. (Darmstadt, Germany).
3.2. Collection of Sillago sihama and Rastrelliger kanagurta Fish
Freshly caught fish samples of Sillago sihama and Rastrelliger kanagurta were purchased from the Qeshm fishmongers’ market and transferred to the laboratory in a flask containing ice at a temperature of 4–10 °C.
3.3. Isolation of Intestinal Bacteria from Sillago sihama and Rastrelliger kanagurta Fish
First, the abdominal surface of the fish was cleaned with 70% alcohol. After opening the stomach of the fish with a surgical blade, the intestines were removed under sterile conditions. After homogenizing and diluting the samples with physiological serum, they were cultured in nutrient agar culture medium and kept in a greenhouse at 30 °C for 48 h in order to isolate bacteria. After the incubation period, the plates were examined morphologically (color and appearance) under the laminar hood, and the colonies were purified.
3.4. Primary Screening of α-Amylase-Producing Bacteria
Bacteria isolated from the intestines of Sillago sihama and Rastrelliger kanagurta were cultured on a special culture medium containing starch (1%) and kept in a greenhouse at 30 °C for 48 h. After the greenhouse period, the growth of bacteria on the starch culture medium was analyzed, and the samples exhibiting the ability to grow in this medium were selected for further analyses. At this stage, Lugol’s solution was poured onto the special culture medium containing starch; then, based on the diameter of the clear halo around the bacterial colony, which indicates starch hydrolysis and enzyme production by bacteria, the α-amylase enzyme-producing colonies were isolated and selected.
3.5. Secondary Screening of α-Amylase-Producing Bacteria and Measurement of Enzyme Activity
The α-amylase enzyme-producing bacteria, which had produced a stronger halo in the primary screening stage, were selected for secondary screening and enzyme activity measurement. At this stage, bacteria were cultured in nutrient broth and incubated in a shaker incubator at 30 °C and 100 rpm. After 24 h, the culture medium containing the grown bacteria was centrifuged at 12,000 rpm for 20 min, and the supernatant was used as a solution containing the α-amylase enzyme in the next stages of the experiment [23]. The Bernfeld method was used to measure alpha-amylase enzyme activity [24]. For this purpose, 400 µL of phosphate buffer solution, 100 µL of α-amylase enzyme extract, and 500 µL of 1% starch were incubated at 60 °C for 20 min. Then, 1 mL of DNS solution was added to the test tube and incubated for 5 min in a boiling water bath. After cooling, 1 mL of distilled water was added to it. After stirring the contents of the absorption tube, the sample was read at a wavelength of 540 nm.
3.6. Identification of Potential α-Amylase Enzyme-Producing Bacteria
In this study, the identification of potential bacteria producing the α-amylase enzyme was carried out by examining phenotypic and biochemical characteristics as well as using 16S rRNA gene analysis. In order to extract the bacterial DNA contents, the boiling method was used [25,26]. Polymerase chain reaction (PCR) was applied to amplify a 1500-bp fragment of the 16S rRNA gene using the extracted DNA of potential α-amylase-producing bacteria (HR13, HR16, HR15, and HR14) by means of forward (5′-AGAGTTTGATCCTGGCTCAG-3′) and reverse (5′-AAGGAGGTGATCCAGCC-3′) primers at a final volume of 50 µL, containing 2 µL of extracted bacterial strain DNA, 0.5 µL of forward primer, 0.5 µL of reverse primer, 25 µL of amplicon master mix solution, and 22 µL of distilled water. The thermal cycling was carried out as follows: an initial denaturation at 95 °C for 1 min, followed by 30 cycles of denaturation at 95 °C for 20 s, annealing at 63 °C for 30 s, extension at 72 °C for 1 min, and the final extension at 72 °C for 5 min.
After checking the quality and quantity of PCR products on 1% agarose gel electrophoresis, they were sent to FAZA Pajooh Co. for double-sided sequencing. The sequences were compared with the 16S rRNA gene sequences of bacteria registered in the NCBI database using the BLAST tool available on the NCBI website. Then, the closest strain was selected based on the S rRNA16 gene sequence and biochemical tests [27,28].
In order to analyze the phylogenetic relationships, the target sequences were assessed and compared in accordance with the NCBI gene bank. In the end, using MEGA4 software and the Neighbor-Joining (NJ) algorithm with bootstrapping, 1000 repetitions of the phylogenetic tree were drawn.
3.7. Effect of pH and Temperature on α-Amylase Activity
The α-amylase enzyme activity was evaluated at a temperature range of 20–90 °C in a 20 mM phosphate buffer (pH 7.4). In order to examine the enzyme activity at any temperature, both the substrate (1% starch) and the enzyme solution (buffer and crude enzyme extract) must reach equilibrium at that temperature before measuring enzyme activity. The relative enzyme activity was measured at different pH values of 2–12 at room temperature. For this purpose, a mixed buffer (containing 25 mM tris-base, glycine, sodium phosphate, and sodium acetate) was prepared and adjusted using NaOH and HCl solutions at different pH values from 2 to 12. In this experiment, a 1% starch solution was also prepared as a substrate, and the enzyme activity was evaluated in the above buffer at different pH values.
3.8. Effects of pH and Temperature on Enzyme Stability
To measure the temperature stability of the enzyme, first, the crude enzyme extracts of both bacteria were placed at 80 and 90 °C for different time intervals (5, 10, 20, 30, 40, 50, and 60 min). Then, 500 µL of the substrate was added to each of the samples, and the resulting mixture was incubated in the assay conditions. Finally, α-amylase activity was stopped using dinitrosalicylic acid reagent and the absorbance of the reaction mixture was read at a wavelength of 540 nm.
In order to measure the pH stability of the enzyme, first, the crude enzyme extracts of both bacteria were exposed to pH values of 8 and 9 for different times (5, 10, 20, 30, 40, 50, and 60 min). Then, 500 µL of the substrate was added to each of the samples, and the resulting mixture was incubated in the assay conditions. Finally, α-amylase activity was measured using the dinitrosalicylic acid reagent and then reading the absorbance of the reaction mixture at a wavelength of 540 nm.
4. Conclusions
The current research aims to isolate and identify regional bacteria generating symbiotic α-amylase enzymes in the intestines of short and talal fishes from Qeshm Island waters. In this study, the symbiotic bacteria Bacillus sp. HR13 and Bacillus sp. HR16 found in the intestines of Sillago sihamas, and Rastrelliger Kanagurta had the highest α-amylase enzyme activity at 60 °C. This implies they could be great choices for purification, mass production, and commercialization for use in the food and detergent industries. In general, the findings of this study show that the Persian Gulf is a rich source of bacterial strains that produce the widely used amylase enzyme, and the fish species Sillago sihamas and Rastrelliger Kanagurta, two of the most abundant species in the Persian Gulf, are rich in bacteria that adapt to the unique conditions of this region.
Author Contributions
Conceptualization and research design, A.H.; experimental, M.R.E.; data analysis, M.R.E. and A.H.; manuscript—writing, M.R.E.; manuscript—editing, A.H. All authors have read and agreed to the published version of the manuscript.
Funding
This research received no external funding.
Data Availability Statement
All data were included in the manuscript.
Acknowledgments
The authors express their gratitude to the research council of the University of Hormozgan for financial support during the course of this project.
Conflicts of Interest
The authors declare no conflict of interest.
References
- Qeshmi, F.I.; Homaei, A.; Fernandes, P.; Hemmati, R.; Dijkstra, B.W.; Khajeh, K. Xylanases from marine microorganisms: A brief overview on scope, sources, features and potential applications. Biochim. Biophys. Acta (BBA) Proteins Proteom. 2020, 1868, 140312. [Google Scholar] [CrossRef] [PubMed]
- Homaei, A. Immobilization of Penaeus merguiensis alkaline phosphatase on gold nanorods for heavy metal detection. Ecotoxicol. Environ. Saf. 2017, 136, 1–7. [Google Scholar] [CrossRef] [PubMed]
- Homaei, A. Purification and biochemical properties of highly efficient alkaline phosphatase from Fenneropenaeus merguiensis brain. J. Mol. Catal. B Enzym. 2015, 118, 16–22. [Google Scholar] [CrossRef]
- Homaei, A.; Qeshmi, F.I. Purification and characterization of a robust thermostable protease isolated from Bacillus subtilis strain HR02 as an extremozyme. J. Appl. Microbiol. 2022, 133, 2779–2789. [Google Scholar] [CrossRef]
- Izadpanah Qeshmi, F.; Homaei, A.; Khajeh, K.; Kamrani, E.; Fernandes, P. Production of a Novel Marine Pseudomonas aeruginosa Recombinant L-Asparaginase: Insight on the Structure and Biochemical Characterization. Mar. Biotechnol. 2022, 24, 559–613. [Google Scholar] [CrossRef]
- Pasalari, A.; Homaei, A. Isolation and Molecular Identification of Xylanase-Producing Bacteria from Ulva flexuosa of the Persian Gulf. Processes 2022, 10, 1834. [Google Scholar] [CrossRef]
- Cahill, M.M. Bacterial flora of fishes: A review. Microb. Ecol. 1990, 19, 21–41. [Google Scholar] [CrossRef]
- Balaji, N.; Rajasekaran, K.M.; Kanipandian, N.; Vignesh, V.; Thirumurugan, R. Isolation and screening of proteolytic bacteria from freshwater fish Cyprinus carpio. Int. Multidiscip. Res. J. 2012, 2, 56–59. [Google Scholar]
- Beygmoradi, A.; Homaei, A.; Hemmati, R.; Santos-Moriano, P.; Hormigo, D.; Fernández-Lucas, J. Marine chitinolytic enzymes, a biotechnological treasure hidden in the ocean? Appl. Microbiol. Biotechnol. 2018, 102, 9937–9948. [Google Scholar] [CrossRef]
- Homaei, A.; Ghanbarzadeh, M.; Monsef, F. Biochemical features and kinetic properties of α-amylases from marine organisms. Int. J. Biol. Macromol. 2016, 83, 306–314. [Google Scholar] [CrossRef]
- Reddy, N.; Nimmagadda, A.; Rao, K.S. An overview of the microbial α-amylase family. Afr. J. Biotechnol. 2003, 2, 645–648. [Google Scholar]
- Sivaramakrishnan, S.; Gangadharan, D.; Nampoothiri, K.M.; Soccol, C.R.; Pandey, A. α-Amylases from microbial sources—An overview on recent developments. Food Technol. Biotechnol. 2006, 44, 173–184. [Google Scholar]
- Makhdoumi, A. Bacterial diversity in south coast of the Caspian Sea: Culture-dependent and culture-independent survey. Casp. J. Environ. Sci. 2018, 16, 259–269. [Google Scholar]
- Jabir, T.; Jesmi, Y.; Vipindas, P.V.; Hatha, A.M. Diversity of nitrogen fixing bacterial communities in the coastal sediments of southeastern Arabian Sea (SEAS). Deep. Sea Res. Part II Top. Stud. Oceanogr. 2018, 156, 51–59. [Google Scholar] [CrossRef]
- Jackson, C.R.; Churchill, P.F.; Roden, E.E. Successional changes in bacterial assemblage structure during epilithic biofilm development. Ecology 2001, 82, 555–566. [Google Scholar] [CrossRef]
- Castro, R.A.; Quecine, M.C.; Lacava, P.T.; Batista, B.D.; Luvizotto, D.M.; Marcon, J.; Ferreira, A.; Melo, I.S.; Azevedo, J.L. Isolation and enzyme bioprospection of endophytic bacteria associated with plants of Brazilian mangrove ecosystem. SpringerPlus 2014, 3, 382. [Google Scholar] [CrossRef]
- Ktari, N.; Ben Khaled, H.; Nasri, R.; Jellouli, K.; Ghorbel, S.; Nasri, M. Trypsin from zebra blenny (Salaria basilisca) viscera: Purification, characterisation and potential application as a detergent additive. Food Chem. 2012, 130, 467–474. [Google Scholar] [CrossRef]
- Debashish, G.; Malay, S.; Barindra, S.; Joydeep, M. Marine enzymes. Mar. Biotechnol. I 2005, 96, 189–218. [Google Scholar]
- Stoll, B.J.; Hansen, N.I.; Sánchez, P.J.; Faix, R.G.; Poindexter, B.B.; Van Meurs, K.P. Early onset neonatal sepsis: The burden of group B Streptococcal and E. coli disease continues. Pediatrics 2011, 127, 817–826. [Google Scholar] [CrossRef]
- Ye, F.; Yang, R.; Hua, X.; Shen, Q.; Zhao, W.; Zhang, W. Modification of stevioside using transglucosylation activity of Bacillus amyloliquefaciens α-amylase to reduce its bitter aftertaste. LWT—Food Sci. Technol. 2013, 51, 524–530. [Google Scholar] [CrossRef]
- Pérez-Carrillo, E.; Serna-Saldívar, S.O.; Alvarez, M.M.; Cortes-Callejas, M.L. Effect of sorghum decortication and use of protease before liquefaction with thermoresistant α-amylase on efficiency of bioethanol production. Cereal. Chem. 2008, 85, 792–798. [Google Scholar] [CrossRef]
- Demirkan, E.S.; Mikami, B.; Adachi, M.; Higasa, T.; Utsumi, S. α-Amylase from B. amyloliquefaciens: Purification, characterization, raw starch degradation and expression in E. coli. Process Biochem. 2005, 40, 2629–2636. [Google Scholar] [CrossRef]
- Dong, G.; Vieille, C.; Savchenko, A.; Zeikus, J.G. Cloning, sequencing, and expression of the gene encoding extracellular alpha-amylase from Pyrococcus furiosus and biochemical characterization of the recombinant enzyme. Appl. Environ. Microbiol. 1997, 63, 3569–3576. [Google Scholar] [CrossRef] [PubMed]
- Bahri, S.; Homaei, A.; Mosaddegh, E. Zinc sulfide-chitosan hybrid nanoparticles as a robust surface for immobilization of Sillago sihama α-amylase. Colloids Surf. B Biointerfaces 2022, 218, 112754. [Google Scholar] [CrossRef] [PubMed]
- Fajingbesi, A.O.; Anzaku, A.A.; Akande, M.; Emmanuel, I.A.; Akwashiki, O. Production of protease enzyme from fish guts using Pseudomonas fluorescens, Enterobacter cloacae and Bacillus megaterium. J. Clin. Path. Lab. Med. 2018, 2, 1–7. [Google Scholar]
- Farha, A.K.; Tr, T.; Purushothaman, A.; Salam, J.A.; Hatha, A.M. Phylogenetic diversity and biotechnological potentials of marine bacteria from continental slope of eastern Arabian Sea. J. Genet. Eng. Biotechnol. 2018, 16, 253–258. [Google Scholar] [CrossRef] [PubMed]
- Ramezani-Pour, N.; Badoei-Dalfard, A.; Namaki-Shoushtari, A.; Karami, Z. Nitrile-metabolizing potential of Bacillus cereus strain FA12; Nitrilase production, purification, and characterization. Biocatal. Biotransformation 2015, 33, 156–166. [Google Scholar] [CrossRef]
- Izadpanah Qeshmi, F.; Javadpour, S.; Malekzadeh, K.; Tamadoni Jahromi, S.; Rahimzadeh, M. Persian gulf is a bioresource of potent L-asparaginase producing bacteria: Isolation & molecular differentiating. Int. J. Environ. Res. 2014, 8, 813–818. [Google Scholar]
Disclaimer/Publisher’s Note: The statements, opinions and data contained in all publications are solely those of the individual author(s) and contributor(s) and not of MDPI and/or the editor(s). MDPI and/or the editor(s) disclaim responsibility for any injury to people or property resulting from any ideas, methods, instructions or products referred to in the content. |
© 2023 by the authors. Licensee MDPI, Basel, Switzerland. This article is an open access article distributed under the terms and conditions of the Creative Commons Attribution (CC BY) license (https://creativecommons.org/licenses/by/4.0/).







